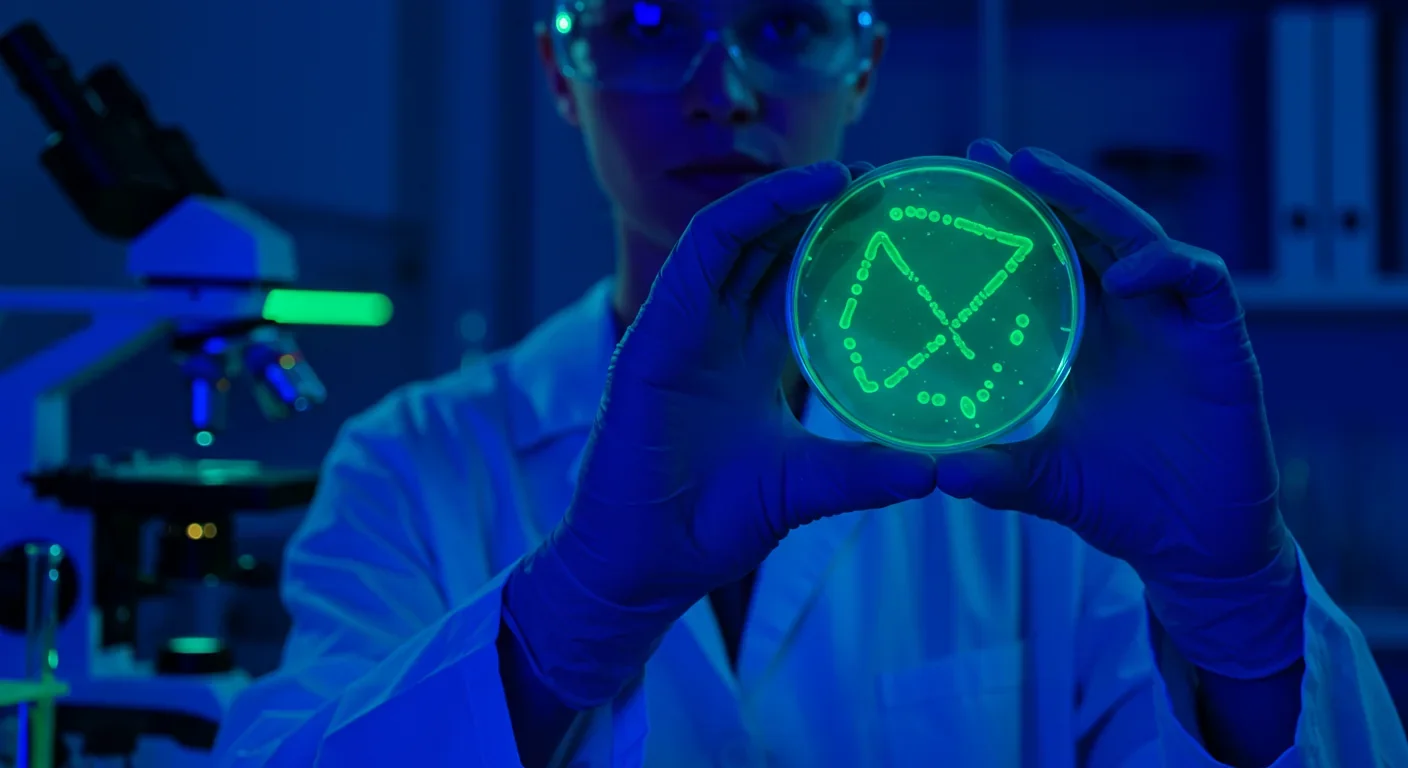

Bombardier Beetle Chemical Defense: Nature's Micro Engine

TL;DR: Bioluminescence—the production of light by living organisms—is one of nature's most elegant survival strategies, evolved independently at least 40 times across bacteria, fungi, insects, and marine life. Using luciferin-luciferase reactions with near-perfect efficiency, organisms create "cold light" for hunting, defense, communication, and mating. Scientists have harnessed these glowing proteins to revolutionize medicine (GFP imaging, drug screening, quantum biosensors) and environmental monitoring. Yet bioluminescent species face existential threats from habitat loss, light pollution, and climate change. Protecting these living lights requires preserving the darkness they need to shine—a challenge that will define whether future generations inherit oceans and forests still illuminated by nature's own chemistry.
In the perpetual darkness of the ocean's depths, a vampire squid doesn't flee predators—it erupts in a cloud of glowing blue mucus. On a Costa Rican forest floor, fireflies conduct synchronized light shows that can be seen for miles. And in laboratories, scientists are using glowing proteins harvested from jellyfish to watch cancer cells divide in real time. Welcome to the luminous world of bioluminescence, where chemistry becomes light, darkness becomes communication, and evolution has written the same brilliant story at least 40 times independently across the tree of life.
Bioluminescence—the production of light by living organisms through chemical reactions—represents one of nature's most elegant solutions to survival. Nearly 90% of deep-sea creatures glow in the dark. Seventy-one species of fungi light up forest floors. And the biochemical machinery that makes it all possible operates at virtually 100% efficiency, producing what scientists call "cold light" with almost no wasted heat. As humanity grapples with energy crises and searches for sustainable technologies, these organisms have been perfecting their craft for hundreds of millions of years.
At its core, bioluminescence is deceptively simple: a molecule called luciferin reacts with oxygen in the presence of an enzyme called luciferase, releasing energy as visible light. But like all elegant systems, the devil—and the beauty—is in the details.
The firefly's light organ contains specialized cells packed with ATP, the same energy currency that powers every cell in your body. When ATP reacts with luciferase, it triggers the oxidation of luciferin, and photons burst forth. The intensity of light is directly proportional to ATP concentration, making this reaction so precise that scientists now use it to detect even a few bacterial cells in water samples—a tool that has revolutionized food safety and environmental monitoring.
But here's where evolution reveals its creative genius: there is no single "luciferin" molecule. Different organisms have independently evolved completely distinct chemical systems. Marine organisms like dinoflagellates use one type of luciferin; fireflies use D-luciferin combined with ATP; and fungi employ an entirely different pathway based on caffeic acid metabolism. The fungal system is so unique that when scientists finally cracked its genetic code, they were able to engineer the first autonomously glowing plants—no external chemicals required.
This biochemical diversity tells us that bioluminescence evolved not once but dozens of times across unrelated lineages. From bacteria to jellyfish to mushrooms, organisms faced with darkness arrived at the same solution through radically different chemical routes. It's convergent evolution at its most spectacular.
What's more remarkable is the original purpose. Recent evidence suggests that bioluminescence may have first evolved not to communicate or hunt, but as a detoxification mechanism. When Earth's atmosphere first accumulated oxygen—a deadly poison to early anaerobic bacteria—some microbes evolved the luciferin-luciferase reaction to safely eliminate toxic oxygen molecules. The light was merely a byproduct. Only later did evolution co-opt this metabolic quirk for signaling, camouflage, and predation.
Turn off every light and descend 1,000 meters below the ocean surface. Your eyes adjust. And then the show begins.
The anglerfish dangles a luminous lure sprouting from its forehead—a fleshy appendage colonized by symbiotic bioluminescent bacteria. In the absolute darkness of the abyssal zone, this glowing bait attracts curious prey directly into the anglerfish's gaping jaws. The bacteria receive shelter and nutrients; the fish receives a living flashlight it never needs to recharge.
Lanternfish, among the most abundant vertebrates on Earth, wear rows of light-producing organs called photophores along their bellies. Through a process called counterillumination, they adjust the intensity of their glow to match the faint downwelling light from above, erasing their silhouettes from predators looking upward. It's adaptive camouflage through mathematics and chemistry.
The vampire squid (despite its ominous name, a gentle filter-feeder) deploys bioluminescence as a defensive smoke bomb. When threatened, it ejects glowing mucus that hangs in the water, confusing predators while the squid vanishes into darkness. No ink—just light.

On land, fireflies perform one of nature's most enchanting spectacles. Each species flashes in a unique pattern—a morse code of love written in yellow-green light. Males cruise above meadows emitting species-specific pulses; females perched in grass reply with precisely timed flashes. This synchrony is so exact that in some tropical species, thousands of fireflies in a single tree will pulse in perfect unison, transforming the canopy into a living lighthouse. The chemical reaction is ATP-driven, energetically expensive, and entirely worth it: successful flashers pass on their genes.
Beneath the leaf litter, the eastern jack-o'-lantern mushroom (Omphalotus illudens) glows a ghostly green. These fungi can emit light for up to 50 hours after being picked—a testament to the durability of their biochemical light engines. Scientists now believe the glow attracts nocturnal insects, which land on the caps and inadvertently carry spores to new locations. The mushroom turns animals into unwitting spore-dispersal couriers, using light as bait.
In New Zealand's Waitomo Caves, glowworms (actually the larvae of fungus gnats) spin sticky silk threads from cave ceilings. Their bioluminescent abdomens glow blue-green, creating an artificial starry sky that lures flying insects into the trap. Tourists pay to glide silently beneath these living constellations—proof that humans, too, are drawn to light in darkness.
And then there are the dinoflagellates, microscopic plankton that bloom in coastal waters by the billions. Disturb the water—run along a beach at night, paddle a kayak, even drag your hand—and the sea erupts in electric blue sparkles. Each cell flashes for a fraction of a second, a chemical alarm triggered by mechanical stress. The evolutionary logic: when a predator (like a small fish) tries to eat you, flash brightly. Larger predators see the flash and eat the fish instead. Bioluminescence as a distress beacon.
In 2008, the Nobel Prize in Chemistry was awarded for the discovery and development of green fluorescent protein (GFP), a molecule isolated from the jellyfish Aequorea victoria. GFP doesn't produce light on its own—it fluoresces, absorbing blue light and re-emitting green. But when researchers figured out how to make GFP brighter and how to attach it to other proteins, they handed science a revolutionary tool: the ability to watch life happen in real time inside living cells.
Today, GFP and its rainbow of engineered variants illuminate everything from cancer metastasis to neuronal firing to the spread of infections. Researchers tag proteins with fluorescent markers and track their movement through tissues, organs, and organisms without killing them. You can watch a tumor grow, a virus invade a cell, or a memory form in a mouse's brain—all because a jellyfish evolved a glowing protein.
But bioluminescence offers more than imaging. Scientists have engineered bioluminescent reporter bacteria that glow in the presence of specific pollutants. Drop them in a water sample contaminated with heavy metals or antibiotics, and they light up, providing a rapid, low-cost contamination test. The same principle now extends to screening drug candidates: researchers insert bioluminescent genes into cells and measure light output to assess cellular health, ATP levels, or enzyme activity. The CellTiter-Glo assay, based on firefly luciferase, has become a workhorse in pharmaceutical research, screening thousands of compounds per day.
A 2025 study took this concept further: researchers screened coral-associated fungi for natural compounds that inhibit β-lactamase, an enzyme that makes bacteria resistant to antibiotics. Using bacteria engineered with bioluminescent stress reporters, they identified fungal metabolites that restored antibiotic effectiveness—potential new weapons against superbugs, discovered through the glow of engineered microbes.
Even more radical: scientists have now created fluorescent biological qubits—quantum sensors built from modified GFP that can detect magnetic and electrical signals inside living cells with unprecedented precision. These protein-based qubits maintain quantum coherence for 16 microseconds, long enough to probe nanoscale biological processes. We're approaching a future where glowing proteins don't just let us see life—they let us measure its quantum foundations.
And then there are the glowing plants. By inserting fungal bioluminescence genes into tobacco plants, researchers have created specimens that glow autonomously, bright enough to read by. The vision: streetlights replaced by trees, living room plants that double as lamps, forests that guide travelers without electricity. It's speculative, yes—but the biochemical proof of concept already exists.
Long before scientists isolated luciferin, humans were captivated—and sometimes terrified—by living light.
In rural Costa Rica, elders tell children that fireflies are the souls of ancestors, guiding lost travelers home. One fisherman recalls a stormy night when coastal lanterns failed; he followed glowing fireflies along the mangroves back to his boat. Whether divine intervention or coincidence, the story underscores a deeper truth: for millennia, bioluminescence has served as a beacon.
The Guarumo tree (Cecropia obtusifolia), which blooms in synchrony with firefly season, is revered as a "tree of good light." Families gather beneath its pale flowers on warm nights to watch the fireflies dance—a ritual that blends ecology, spirituality, and wonder.
Fungal bioluminescence has inspired darker tales. The faint green glow of mycelium on rotting wood—called "foxfire"—was interpreted by medieval Europeans as the lanterns of fairies or the souls of the unbaptized. The honey fungus Armillaria ostoyae, one of the largest living organisms on Earth (a single specimen in Oregon spans 2,384 acres), glows faintly in its underground networks. Walking through a dark forest and glimpsing that ghostly luminescence must have felt like stepping into another world.
In the Philippines, fishermen have long known that certain seas glow at night, a phenomenon now understood to be dinoflagellate blooms. But traditional stories framed the light as the breath of sea spirits or the tears of drowned sailors—explanations that, while scientifically inaccurate, reflect a profound recognition that the ocean is alive and responsive.
Modern science doesn't erase the magic; it deepens it. Knowing how a firefly glows doesn't make the sight any less wondrous. If anything, understanding the ATP-driven chemistry and evolutionary history makes the light more astonishing.

Bioluminescence is fragile.
Firefly populations are collapsing worldwide, victims of three interconnected threats: habitat loss, pesticide use, and light pollution. Fireflies spend most of their lives as soft-bodied larvae in soil and leaf litter, where they hunt snails and slugs. Urbanization paves over these habitats. Pesticides seep into the ground, poisoning larvae. And artificial light—streetlamps, neon signs, porch bulbs—drowns out the delicate flash patterns males and females use to find each other.
Studies show that even moderate light pollution reduces firefly mating success by up to 80%. Flash signals become invisible against the glare. Reproductive rates plummet. In some regions, species that once illuminated summer nights have vanished entirely within a generation.
In the ocean, bioluminescent ecosystems face equally severe pressures. Deep-sea mining threatens abyssal habitats where bioluminescence is the primary form of communication. These ecosystems, largely unexplored and poorly understood, could be obliterated before we even catalog their inhabitants.
Climate change is altering ocean chemistry and temperature, disrupting the symbiotic relationships that many bioluminescent organisms depend on. The Hawaiian bobtail squid, which houses bioluminescent Aliivibrio fischeri bacteria in a specialized light organ, relies on precise environmental cues to establish that symbiosis. Warming waters and acidification could break the partnership.
Dinoflagellate blooms—often bioluminescent—are becoming more frequent and intense due to nutrient runoff from agriculture. While these "red tides" create stunning nighttime displays, they also produce toxins that kill fish, marine mammals, and seabirds. The EPA warns that climate change and coastal pollution are making harmful algal blooms a growing crisis.
Coastal light pollution affects marine life, too. Species that rely on darkness for communication and hunting—like bioluminescent squid and fish—are disoriented by artificial lighting. Just as fireflies lose their signals in lit suburbs, marine creatures lose theirs in illuminated harbors.
Conservation efforts are underway, though they face uphill battles.
Dark-sky initiatives aim to reduce light pollution by promoting shielded, downward-facing streetlights and encouraging communities to dim unnecessary lighting at night. These efforts benefit not just bioluminescent organisms but also migratory birds, sea turtles, and human health (light pollution disrupts circadian rhythms).
Firefly tourism has emerged as a double-edged sword. In places like Costa Rica, Japan, and the Great Smoky Mountains, firefly watching generates revenue that incentivizes habitat protection. But unregulated tourism can trample habitats and introduce more light pollution. Sustainable ecotourism—small groups, red flashlights, strict no-light policies—offers a model.
Marine protected areas (MPAs) provide refuges for bioluminescent species, though enforcement remains patchy. The deep sea, where bioluminescence is most common, remains largely unprotected. International treaties governing deep-sea mining are weak, and corporate interest in seabed minerals is surging.
Scientists are also racing to catalog bioluminescent biodiversity before it disappears. Expeditions using submersibles and remote-operated vehicles are documenting species in the Mariana Trench, the Mid-Atlantic Ridge, and Antarctic waters—places where bioluminescence is ubiquitous but human presence is minimal. Each expedition discovers dozens of new glowing species, a reminder of how much remains unknown.
Perhaps most importantly, bioluminescent organisms are being positioned as indicators of ecosystem health. Population declines in fireflies signal broader habitat degradation. Changes in dinoflagellate bloom patterns reflect nutrient pollution and climate shifts. The presence or absence of bioluminescence offers a visible, visceral measure of environmental change—one that resonates with the public in ways that abstract data often cannot.
Bioluminescence is more than a scientific curiosity or an ecotourism attraction. It's a reminder that life, even in the darkest places, finds ways to shine.
The biochemical pathways that produce cold light with near-perfect efficiency could inspire the next generation of sustainable lighting. The genetic tools derived from GFP have already transformed medicine and will continue to do so. The ecological roles of bioluminescence—communication, camouflage, predation, symbiosis—illustrate the intricate, interconnected strategies life employs to survive.
But bioluminescence also poses a challenge: can we preserve the darkness necessary for these lights to matter? A firefly's flash means nothing in a floodlit parking lot. A glowing mushroom goes unnoticed under LED streetlights. The ocean's living constellations disappear when coastal cities never sleep.
The coming decades will determine whether future generations inherit a world still punctuated by natural light—or one where artificial glow has rendered the living kind invisible. The chemistry of bioluminescence is solved. The engineering applications are emerging. The cultural and spiritual significance is timeless. What remains uncertain is whether we will protect the conditions—darkness, habitat, clean water—that allow bioluminescence to endure.
In the words of marine biologist Dr. Ayana Elizabeth Johnson, the ocean holds a third of the climate solutions we need. Protecting bioluminescent ecosystems is part of that equation. So is dimming our lights, preserving wild places, and recognizing that some of nature's most profound communication happens in wavelengths we can barely see.
The vampire squid's glowing mucus. The firefly's synchronized pulse. The mushroom's patient glow. These are not mere spectacles. They are survival strategies honed over hundreds of millions of years—strategies we are only beginning to understand, strategies we risk extinguishing before we fully appreciate them, strategies that, if we listen closely, might just light the way forward.

Recent breakthroughs in fusion technology—including 351,000-gauss magnetic fields, AI-driven plasma diagnostics, and net energy gain at the National Ignition Facility—are transforming fusion propulsion from science fiction to engineering frontier. Scientists now have a realistic pathway to accelerate spacecraft to 10% of light speed, enabling a 43-year journey to Alpha Centauri. While challenges remain in miniaturization, neutron management, and sustained operation, the physics barriers have ...

Epigenetic clocks measure DNA methylation patterns to calculate biological age, which predicts disease risk up to 30 years before symptoms appear. Landmark studies show that accelerated epigenetic aging forecasts cardiovascular disease, diabetes, and neurodegeneration with remarkable accuracy. Lifestyle interventions—Mediterranean diet, structured exercise, quality sleep, stress management—can measurably reverse biological aging, reducing epigenetic age by 1-2 years within months. Commercial ...

Data centers consumed 415 terawatt-hours of electricity in 2024 and will nearly double that by 2030, driven by AI's insatiable energy appetite. Despite tech giants' renewable pledges, actual emissions are up to 662% higher than reported due to accounting loopholes. A digital pollution tax—similar to Europe's carbon border tariff—could finally force the industry to invest in efficiency technologies like liquid cooling, waste heat recovery, and time-matched renewable power, transforming volunta...

Humans are hardwired to see invisible agents—gods, ghosts, conspiracies—thanks to the Hyperactive Agency Detection Device (HADD), an evolutionary survival mechanism that favored false alarms over fatal misses. This cognitive bias, rooted in brain regions like the temporoparietal junction and medial prefrontal cortex, generates religious beliefs, animistic worldviews, and conspiracy theories across all cultures. Understanding HADD doesn't eliminate belief, but it helps us recognize when our pa...

The bombardier beetle has perfected a chemical defense system that human engineers are still trying to replicate: a two-chamber micro-combustion engine that mixes hydroquinone and hydrogen peroxide to create explosive 100°C sprays at up to 500 pulses per second, aimed with 270-degree precision. This tiny insect's biochemical marvel is inspiring revolutionary technologies in aerospace propulsion, pharmaceutical delivery, and fire suppression. By 2030, beetle-inspired systems could position sat...

The U.S. faces a catastrophic care worker shortage driven by poverty-level wages, overwhelming burnout, and systemic undervaluation. With 99% of nursing homes hiring and 9.7 million openings projected by 2034, the crisis threatens patient safety, family stability, and economic productivity. Evidence-based solutions—wage reforms, streamlined training, technology integration, and policy enforcement—exist and work, but require sustained political will and cultural recognition that caregiving is ...

Every major AI model was trained on copyrighted text scraped without permission, triggering billion-dollar lawsuits and forcing a reckoning between innovation and creator rights. The future depends on finding balance between transformative AI development and fair compensation for the people whose work fuels it.